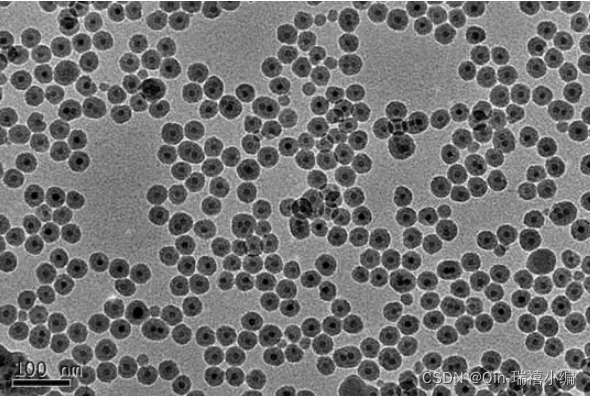

牛血清白蛋白化学包裹Fe3O4磁性颗粒Fe3O4-BSA
采用化学共沉淀法制备了纳米四氧化三铁(Fe3O4)磁性颗粒,然后用牛血清白蛋白对表面氨基化后的磁性颗粒进行了化学修饰。利用X-射线衍射、透射电子显微镜、红外光谱、接触角仪以及样品磁振动仪等手段对改性前后磁性颗粒的结构和性能进行了表征。结果表明,改性使纳米磁性颗粒具有良好的分散性,亲水性能大大增强,而饱和磁化强度变化不大,氨基硅烷的引入有利于提高蛋白在磁性颗粒表面的包覆效率,改性后的磁性颗粒可以作为靶向载体。
基于牛血清白蛋白包裹的金纳米簇和四氧化三铁二氧化硅核壳纳米粒子复合材料:合成了一
本文来自互联网用户投稿,文章观点仅代表作者本人,不代表本站立场,不承担相关法律责任。如若转载,请注明出处。 如若内容造成侵权/违法违规/事实不符,请点击【内容举报】进行投诉反馈!
